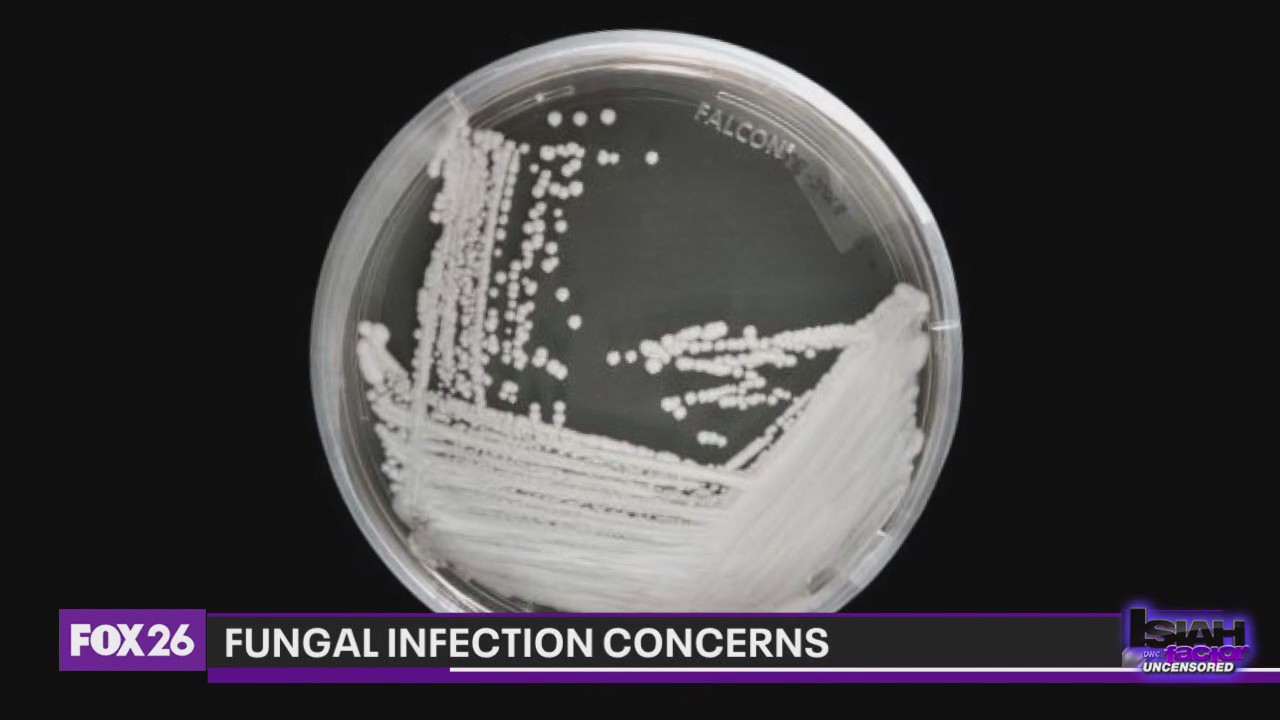
CDC expresses concern over dangerous fungus

Is there a violence problem in the Black community?
Our panelists continue our conversation about addressing a possible violence problem in the Black community.
Our panelists continue our conversation about addressing a possible violence problem in the Black community.
Rough sex gone too far? Man accused of choking girlfriend to death
Relationship and sex coach Beth Liebling joins The Isiah Factor: Uncensored to talk about erotic asphyxiation.
Relationship and sex coach Beth Liebling joins The Isiah Factor: Uncensored to talk about erotic asphyxiation.
Music legend Al B. Sure! talks life, career, lasting legacy
The headline speaks for itself. R&B and New Jack Swing icon Al B. Sure! makes his debut on The Isiah Factor: Uncensored.
The headline speaks for itself. R&B and New Jack Swing icon Al B. Sure! makes his debut on The Isiah Factor: Uncensored.
Houston Astros release exclusive 'Gold Rush' merchandise
Those Astros fans don't play about their team! Isiah Carey speaks to them at the midnight release of new exclusive merchandise.
Those Astros fans don't play about their team! Isiah Carey speaks to them at the midnight release of new exclusive merchandise.
Dangers of illegal street racing
More than 100 arrests were made in connection to illegal street racing in Harris County over the weekend.
More than 100 arrests were made in connection to illegal street racing in Harris County over the weekend.
Angela After Dark: Benefits of Microdosing
Can psychedelics be used to improve physical and mental health?
Can psychedelics be used to improve physical and mental health?
Woman at center of polyamorous trio speaks on life with husbands
Two men, one woman, two marriages! The stars of TLC's new series 'Seeking Brother Husband' share details about their relationships.
Two men, one woman, two marriages! The stars of TLC's new series 'Seeking Brother Husband' share details about their relationships.
Ja Morant returns after being suspended by NBA
A suspension for athlete Ja Morant has ended. As the controversial basketball player returns to the game, we ask if hip-hop has a negative impact on his behavior.
A suspension for athlete Ja Morant has ended. As the controversial basketball player returns to the game, we ask if hip-hop has a negative impact on his behavior.
Tekashi69 attacked inside Florida gym
Isiah Factor: Uncensored DJ's weigh in on the assault of rapper Tekashi69.
Isiah Factor: Uncensored DJ's weigh in on the assault of rapper Tekashi69.
Indictment vote on former President Trump delayed
Are there any fears among the Manhattan grand jury to indict former President Donald Trump?
Are there any fears among the Manhattan grand jury to indict former President Donald Trump?
Laid off workers no longer have to stay silent
Workers now have the right to run their mouth after being laid off from a job.
Workers now have the right to run their mouth after being laid off from a job.
Hairstylists critiqued for excessive fees, attitude towards customers
Let's keep it real. Are these new age stylists too difficult to deal with?
Let's keep it real. Are these new age stylists too difficult to deal with?
Protection from app scams
Scammers are getting more creative in their attempts to steal money.
Scammers are getting more creative in their attempts to steal money.
CDC expresses concern over dangerous fungus
The CDC is calling a fungal spread a threat to public health.
The CDC is calling a fungal spread a threat to public health.
Fake photos of former President Trump getting arrested goes viral
Were you duped into believing those photos of President Trump being taken into police were real? Well, you aren't alone.
Were you duped into believing those photos of President Trump being taken into police were real? Well, you aren't alone.
Bun B celebrates 50th birthday
Rap legend Bun B celebrated the big 50 over the weekend. Coco Dominguez takes inside the surprise birthday bash.
Rap legend Bun B celebrated the big 50 over the weekend. Coco Dominguez takes inside the surprise birthday bash.
Fitness junkies incorporate dog food in their diet
Is the protein in dog food really worth those body goals?
Is the protein in dog food really worth those body goals?
Spring Break violence in Miami Beach
With the mayhem in Miami Beach this Spring Break, we ask what needs to be done to put some Black youth on the right track.
With the mayhem in Miami Beach this Spring Break, we ask what needs to be done to put some Black youth on the right track.
Subscription service allows Instagram and Facebook users to pay for verification
If you've been dreaming about having your Instagram handle verified, you can now apply. You don't have to be a celebrity, but that blue tick will cost. In this segment, we ask if the new service takes away from the prestige of being verified.
If you've been dreaming about having your Instagram handle verified, you can now apply. You don't have to be a celebrity, but that blue tick will cost. In this segment, we ask if the new service takes away from the prestige of being verified.
Benefits of employers being transparent about pay
More employers nationwide are being upfront about salary figures on job postings.
More employers nationwide are being upfront about salary figures on job postings.